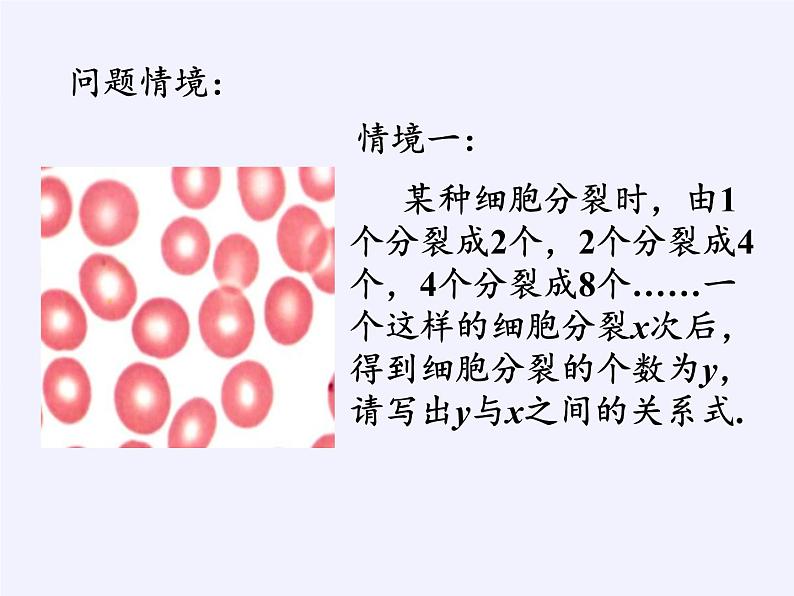

苏教版必修13.1.2 指数函数示范课ppt课件
展开某种细胞分裂时,由1个分裂成2个,2个分裂成4个,4个分裂成8个……一个这样的细胞分裂x次后,得到细胞分裂的个数为y,请写出y与x之间的关系式.
某放射性物质不断衰变为其他物质,每经过1年,这种物质剩留的质量是原来的50%,现有该物质质量为1,经过x年的剩留量为y,请写出y与x之间的关系式.
1、函数 与函数 具有哪些相同的特征?
2、你能否写出类似结构的函数表达式?
3、能否将上述几个具体的函数表达式统一写成一般的函数表达式呢?
一般地,函数 叫做指数函数,它的定义域是 .
思考:函数 y=x0.6 是指数函数吗?
1、我们在前面函数章节中研究了函数的哪些性质?
2、我们在前面函数章节中通过怎样的方法研究函数的性质?
请用列表描点的方法分别作出指数函数 的图象.
大1增,小1减,图象恒过(0,1)点;左右无限上冲天,永与横轴不沾边.
1、比较下列各组数中两个值的大小(1)1.52,1.53 (2)1.52.5 ,1.53.2 (3)0.5-1.2 ,0.5-1.5 (4)1.50.3, 0.81.2
2、比较下列各组数中两个值的大小:
3、求满足下列条件的实数
的取值范围是____.
1、知识点上:(1)学习了研究具体函数的方式; (2)学习了指数函数的图象与性质.
2、思想方法上:(1)特殊→一般→特殊;(2)分类讨论;(3)构造函数; (4)数形结合 .
P54 习题2.2(2)/2,3,4
苏教版必修1第3章 指数函数、对数函数和幂函数3.1 指数函数3.1.2 指数函数说课课件ppt: 这是一份苏教版必修1第3章 指数函数、对数函数和幂函数3.1 指数函数3.1.2 指数函数说课课件ppt,共23页。PPT课件主要包含了a的n次实数方根,增函数,减函数,0+∞,典例分析,举一反三,答案①,考点演练等内容,欢迎下载使用。
必修1第3章 指数函数、对数函数和幂函数3.1 指数函数3.1.2 指数函数授课课件ppt: 这是一份必修1第3章 指数函数、对数函数和幂函数3.1 指数函数3.1.2 指数函数授课课件ppt,共19页。PPT课件主要包含了情境引入,指数函数的定义,定义建构,当a0时,当a1时,概念辨析,定义应用,性质探索,●图象特征,指数函数的性质等内容,欢迎下载使用。
苏教版必修13.1.2 指数函数示范课课件ppt: 这是一份苏教版必修13.1.2 指数函数示范课课件ppt,共19页。PPT课件主要包含了情境问题,两个函数关系式,学生活动,yax,数学建构,指数函数的定义,数学应用,探求图象,◆图象都在x轴上方,回顾小结等内容,欢迎下载使用。













